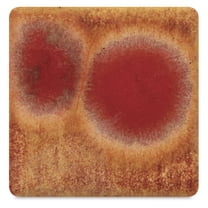
Mayco Jungle Gems Crystal Glaze - Dragon's Breath, Pint

Hero image 0 of Mayco Jungle Gems Crystal Glaze 12-Color Set #1 - Pint Jars, 0 of 1
Mayco Jungle Gems Crystal Glaze 12-Color Set #1 - Pint Jars
(No ratings yet)
Key item features
- Crystal Composition: Jungle Gems Crystal Glazes incorporate glass frit crystals and specks that melt during firing, creating dramatic, colorful effects as they bloom and spread.
- Fluid Base: The glazes feature a fluid base, promoting greater crystal flow and movement during the firing process.
- Application Surfaces: These glazes are suitable for application on earthenware, stoneware, or porcelain clay bodies.
- Application Method: For optimal results, apply three coats with a fan brush on Cone 04 bisque, allowing drying time between coats, and avoid heavy crystal concentration near the piece's bottom.
- Firing Range: Glazes can be fired from Cone 06, with Cone 6 and Cone 10 firings yielding interesting effects.
- Color Variety: The set includes 12 colors: royal fantasy, bloomin blue, pistachio, blue caprice, sassy orange, firecracker, blue azure, mystic jade, kaleidoscope, black iris, mocha marble, and masquerade.
- Safety Certification: All colors are AP Seal certified and non-toxic, though not dinnerware safe due to post-firing surface characteristics.
Generated by AI
Specs
- Ceramics glaze typeCeramic Glaze
- ColorMulticolor
- FinishCrystal Glaze
- BrandMayco
- SizePint jars
- Rec. useBrush
Current price is USD$239.89
Price when purchased online
- Free shipping
Free 30-day returns
How do you want your item?
Columbus, 43215
Arrives between Feb 13 - Feb 17
|Sold and shipped by United Art and Education
4.380499405469679 stars out of 5, based on 841 seller reviews(4.4)841 seller reviews
Free 30-day returns
Compare with similar items
| Product | Viewing this itemMayco Jungle Gems Crystal Glaze 12-Color Set #1 - Pint Jars  $239.89 current price $239.89 | Non-Toxic Crystal Magic Glaze, Set - 12  Now $76.50 current price Now $76.50, Was $94.20$94.20 | Mayco Jungle Gems Crystal Glaze - Berry Tart, Pint  Now $17.73 current price Now $17.73, Was $28.76$28.76 | Mayco Jungle Gems Crystal Glaze - Mixed Melon, Pint  $17.73 current price $17.7315 out of 5 Stars. 1 reviews | True Flow Non-Toxic Crystal Magic Glaze Set 1 Pint Set - 12  $206.33 current price $206.33 | Mayco Jungle Gems Crystal Glaze - Peacock Green, Pint  $17.73 current price $17.73 | Mayco Jungle Gems Crystal Glaze - Masquerade, Pint  $17.73 current price $17.73 | Mayco 2003170 1 Pint Jungle Gems Glaze, Assorted Color - Set of 12  $267.47 current price $267.47 | Mayco Jungle Gems Crystal Glaze - Dragon's Breath, Pint  $17.73 current price $17.7315 out of 5 Stars. 1 reviews | Mayco Stoneware Classic Glaze - Micro Pearl, Pint  $16.00 current price $16.00 |
|---|
| Ceramics glaze type | Ceramic GlazeMayco Jungle Gems Crystal Glaze 12-Color Set #1 - Pint Jars | -Non-Toxic Crystal Magic Glaze, Set - 12 | Lead-Free GlazeMayco Jungle Gems Crystal Glaze - Berry Tart, Pint | Ceramic GlazeMayco Jungle Gems Crystal Glaze - Mixed Melon, Pint | Lead-Free GlazeTrue Flow Non-Toxic Crystal Magic Glaze Set 1 Pint Set - 12 | Ceramic GlazeMayco Jungle Gems Crystal Glaze - Peacock Green, Pint | Ceramic GlazeMayco Jungle Gems Crystal Glaze - Masquerade, Pint | Ceramic GlazeMayco 2003170 1 Pint Jungle Gems Glaze, Assorted Color - Set of 12 | Ceramic GlazeMayco Jungle Gems Crystal Glaze - Dragon's Breath, Pint | Stoneware GlazeMayco Stoneware Classic Glaze - Micro Pearl, Pint |
|---|---|---|---|---|---|---|---|---|---|---|
| Color | MulticolorMayco Jungle Gems Crystal Glaze 12-Color Set #1 - Pint Jars | BlueNon-Toxic Crystal Magic Glaze, Set - 12 | Berry TartMayco Jungle Gems Crystal Glaze - Berry Tart, Pint | Mixed MelonMayco Jungle Gems Crystal Glaze - Mixed Melon, Pint | BlueTrue Flow Non-Toxic Crystal Magic Glaze Set 1 Pint Set - 12 | Peacock GreenMayco Jungle Gems Crystal Glaze - Peacock Green, Pint | MasqueradeMayco Jungle Gems Crystal Glaze - Masquerade, Pint | MulticolorMayco 2003170 1 Pint Jungle Gems Glaze, Assorted Color - Set of 12 | Dragons BreathMayco Jungle Gems Crystal Glaze - Dragon's Breath, Pint | Micro PearlMayco Stoneware Classic Glaze - Micro Pearl, Pint |
| Finish | Crystal GlazeMayco Jungle Gems Crystal Glaze 12-Color Set #1 - Pint Jars | -Non-Toxic Crystal Magic Glaze, Set - 12 | GlossMayco Jungle Gems Crystal Glaze - Berry Tart, Pint | Crystal GlazeMayco Jungle Gems Crystal Glaze - Mixed Melon, Pint | CrystalTrue Flow Non-Toxic Crystal Magic Glaze Set 1 Pint Set - 12 | Semi-OpaqueMayco Jungle Gems Crystal Glaze - Peacock Green, Pint | GlossMayco Jungle Gems Crystal Glaze - Masquerade, Pint | -Mayco 2003170 1 Pint Jungle Gems Glaze, Assorted Color - Set of 12 | -Mayco Jungle Gems Crystal Glaze - Dragon's Breath, Pint | -Mayco Stoneware Classic Glaze - Micro Pearl, Pint |
| Size | Pint jarsMayco Jungle Gems Crystal Glaze 12-Color Set #1 - Pint Jars | PintNon-Toxic Crystal Magic Glaze, Set - 12 | 16 oz (473 ml)Mayco Jungle Gems Crystal Glaze - Berry Tart, Pint | 16 oz (473 ml)Mayco Jungle Gems Crystal Glaze - Mixed Melon, Pint | 1 PintTrue Flow Non-Toxic Crystal Magic Glaze Set 1 Pint Set - 12 | 16 oz (473 ml)Mayco Jungle Gems Crystal Glaze - Peacock Green, Pint | 16 oz (473 ml)Mayco Jungle Gems Crystal Glaze - Masquerade, Pint | 1 PintMayco 2003170 1 Pint Jungle Gems Glaze, Assorted Color - Set of 12 | 16 oz (473 ml)Mayco Jungle Gems Crystal Glaze - Dragon's Breath, Pint | PintMayco Stoneware Classic Glaze - Micro Pearl, Pint |
Now hiding additional rows in the Table
About this item
Product details
JUNGLE GEM GLAZE KIT 12 PINT
Jungle Gems Crystal Glazes contain glass frit crystals and specks that melt during the firing process. As the crystals "bloom" and spread they produce dramatic, colorful effects. Feature a fluid base glaze which allows for greater crystal flow and movement. Apply to earthenware, stoneware or porcelain clay bodies. For best results, shake jar and stir well before each application to keep the crystals evenly distributed. Using a fan brush, apply three coats on Cone 04 bisque, allowing to dry between each coat. Avoid placing a heavy concentration of crystals near the bottom of the piece. Can be fired from Cone 06; Cone 6 and Cone 10 firings product interesting effects. 12 colors: royal fantasy, bloomin blue, pistachio, blue caprice, sassy orange, firecracker, blue azure, mystic jade, kaleidoscope, black iris, mocha marble and masquerade. All colors are AP Seal, non-toxic. Not dinnerware safe because of the surface characteristics of the glazes after firing.
info:
We aim to show you accurate product information. Manufacturers, suppliers and others provide what you see here, and we have not verified it.
Warranty
Warranty information
Please be aware that the warranty terms on items offered for sale by third party Marketplace sellers may differ from those displayed in this section (if any). To confirm warranty terms on an item offered for sale by a third party Marketplace seller, please use the 'Contact seller' feature on the third party Marketplace seller's information page and request the item's warranty terms prior to purchase.
Similar items you might like
Based on what customers bought
Non-Toxic Crystal Magic Glaze, Set - 12 $76.50 Was $94.20
 Now$7650current price Now $76.50, Was $94.20$94.20
Now$7650current price Now $76.50, Was $94.20$94.20Non-Toxic Crystal Magic Glaze, Set - 12
Shipping, arrives in 3+ daysMayco Jungle Gems Crystal Glaze - Berry Tart, Pint $17.73 Was $28.76
 Now$1773current price Now $17.73, Was $28.76$28.76+$9.95 shipping
Now$1773current price Now $17.73, Was $28.76$28.76+$9.95 shippingMayco Jungle Gems Crystal Glaze - Berry Tart, Pint
Shipping, arrives in 3+ daysMayco Jungle Gems Crystal Glaze - Mixed Melon, Pint $17.73
 $1773current price $17.73+$9.95 shipping
$1773current price $17.73+$9.95 shippingMayco Jungle Gems Crystal Glaze - Mixed Melon, Pint
15 out of 5 Stars. 1 reviewsShipping, arrives in 3+ daysTrue Flow Non-Toxic Crystal Magic Glaze Set 1 Pint Set - 12 $206.33
 $20633current price $206.33
$20633current price $206.33True Flow Non-Toxic Crystal Magic Glaze Set 1 Pint Set - 12
Shipping, arrives in 3+ daysMayco Jungle Gems Crystal Glaze - Peacock Green, Pint $17.73
 $1773current price $17.73+$9.95 shipping
$1773current price $17.73+$9.95 shippingMayco Jungle Gems Crystal Glaze - Peacock Green, Pint
Shipping, arrives in 3+ daysMayco Jungle Gems Crystal Glaze - Masquerade, Pint $17.73
 $1773current price $17.73+$9.95 shipping
$1773current price $17.73+$9.95 shippingMayco Jungle Gems Crystal Glaze - Masquerade, Pint
Shipping, arrives in 3+ daysMayco 2003170 1 Pint Jungle Gems Glaze, Assorted Color - Set of 12 $267.47
 $26747current price $267.47
$26747current price $267.47Mayco 2003170 1 Pint Jungle Gems Glaze, Assorted Color - Set of 12
Shipping, arrives in 3+ daysMayco Stoneware Classic Glaze - Micro Pearl, Pint $16.00
 $1600current price $16.00+$9.95 shipping
$1600current price $16.00+$9.95 shippingMayco Stoneware Classic Glaze - Micro Pearl, Pint
Shipping, arrives in 3+ daysMayco Jungle Gems Crystal Glaze - Dragon's Breath, Pint $17.73
$1773current price $17.73+$9.95 shipping
$1773current price $17.73+$9.95 shippingMayco Jungle Gems Crystal Glaze - Dragon's Breath, Pint
15 out of 5 Stars. 1 reviewsShipping, arrives in 3+ daysMayco Elements Glaze - Green Sapphire, Pint $16.00
 $1600current price $16.00+$9.95 shipping
$1600current price $16.00+$9.95 shippingMayco Elements Glaze - Green Sapphire, Pint
Shipping, arrives in 3+ daysMayco Jungle Gems Crystal Glaze Set 4 oz- 12 Jars Classroom Pack for Ceramics, Pottery, Painting, Artists, Teachers $77.89
 $7789current price $77.89
$7789current price $77.89Mayco Jungle Gems Crystal Glaze Set 4 oz- 12 Jars Classroom Pack for Ceramics, Pottery, Painting, Artists, Teachers
Shipping, arrives in 3+ daysMayco Jungle Gems Crystal Glaze - Seawind, Pint $17.73 Was $36.93
 Now$1773current price Now $17.73, Was $36.93$36.93+$9.95 shipping
Now$1773current price Now $17.73, Was $36.93$36.93+$9.95 shippingMayco Jungle Gems Crystal Glaze - Seawind, Pint
Shipping, arrives in 3+ daysMayco Jungle Gems Crystal Glaze - Seafoam, Pint $17.73
 $1773current price $17.73+$9.95 shipping
$1773current price $17.73+$9.95 shippingMayco Jungle Gems Crystal Glaze - Seafoam, Pint
Shipping, arrives in 3+ daysMayco Jungle Gems Crystal Glaze - Blueberry Bubblegum, Pint $17.73 Was $28.76
 Now$1773current price Now $17.73, Was $28.76$28.76+$9.95 shipping
Now$1773current price Now $17.73, Was $28.76$28.76+$9.95 shippingMayco Jungle Gems Crystal Glaze - Blueberry Bubblegum, Pint
Shipping, arrives in 3+ daysMayco Jungle Gems Crystal Glaze - Pistachio, Pint $17.73
 $1773current price $17.73+$9.95 shipping
$1773current price $17.73+$9.95 shippingMayco Jungle Gems Crystal Glaze - Pistachio, Pint
Shipping, arrives in 3+ daysMayco Lead-Free Jungle Gems Crystal Glazes - Class Pack #1 - Pint, Set of 6 $97.34
 $9734current price $97.34
$9734current price $97.34Mayco Lead-Free Jungle Gems Crystal Glazes - Class Pack #1 - Pint, Set of 6
Shipping, arrives in 3+ daysMayco Jungle Gems Crystal Glaze - Blue Azure, Pint $17.73
 $1773current price $17.73+$9.95 shipping
$1773current price $17.73+$9.95 shippingMayco Jungle Gems Crystal Glaze - Blue Azure, Pint
Shipping, arrives in 3+ daysSax Colorburst Glazes, 1 Pint Containers, Assorted Colors, Set of 12 $195.91
 $19591current price $195.91
$19591current price $195.91Sax Colorburst Glazes, 1 Pint Containers, Assorted Colors, Set of 12
15 out of 5 Stars. 1 reviewsShipping, arrives in 3+ daysMayco Stoneware Crystal Glaze, Celadon Bloom SW150, 1 Pint $16.00
 $1600current price $16.00+$9.95 shipping
$1600current price $16.00+$9.95 shippingMayco Stoneware Crystal Glaze, Celadon Bloom SW150, 1 Pint
Shipping, arrives in 3+ days
Popular items in this category
Best selling items that customers love
Mayco Designer Liner, Assorted Colors, 1-1/4 Ounces, Set of 6 $33.89
 $3389current price $33.89
$3389current price $33.89Mayco Designer Liner, Assorted Colors, 1-1/4 Ounces, Set of 6
45 out of 5 Stars. 4 reviewsShipping, arrives in 3+ daysClearance Pottery Tools Ceramic Repair Kit, Epoxy Glue, Gold & Silver Powder, Cup for DIY Beginners, Restore Porcelain & Clay $22.94 Was $26.99
Clearance SponsoredNow$2294current price Now $22.94, Was $26.99$26.99
SponsoredNow$2294current price Now $22.94, Was $26.99$26.99Pottery Tools Ceramic Repair Kit, Epoxy Glue, Gold & Silver Powder, Cup for DIY Beginners, Restore Porcelain & Clay
11 out of 5 Stars. 1 reviewsSave withShipping, arrives in 3+ daysNuvo Crystal Glaze-50ml $9.35 Was $11.50
 Now$935current price Now $9.35, Was $11.50$11.50
Now$935current price Now $9.35, Was $11.50$11.50Nuvo Crystal Glaze-50ml
14 out of 5 Stars. 1 reviewsShipping, arrives in 3+ daysSax Crystal Magic Glazes, 4 Ounce Jars, Assorted Colors, Set of 12 $68.53
 $6853current price $68.53
$6853current price $68.53Sax Crystal Magic Glazes, 4 Ounce Jars, Assorted Colors, Set of 12
54.4 out of 5 Stars. 5 reviewsShipping, arrives in 3+ days456564 Sculpey Glaze 1 Ounce-Glossy $14.92
 $1492current price $14.92
$1492current price $14.92456564 Sculpey Glaze 1 Ounce-Glossy
Shipping, arrives in 3+ daysColorobbia® Liquid 8% Bright Gold Overglaze for Kiln-Fired Ceramics (Pkg/1) $55.50
 2 optionsAvailable in additional 2 options$5550current price $55.50
2 optionsAvailable in additional 2 options$5550current price $55.50Colorobbia® Liquid 8% Bright Gold Overglaze for Kiln-Fired Ceramics (Pkg/1)
64.3 out of 5 Stars. 6 reviewsShipping, arrives in 3+ daysSpeedball Art 16 oz. (pint) Earthenware Glaze--Yellow $24.89 $24.89/count
 $2489current price $24.89$24.89/count
$2489current price $24.89$24.89/countSpeedball Art 16 oz. (pint) Earthenware Glaze--Yellow
Shipping, arrives in 3+ daysMainstays 14oz Citrus & Citronella Outdoor Fragranced Candle $5.56
 $556current price $5.56
$556current price $5.56Mainstays 14oz Citrus & Citronella Outdoor Fragranced Candle
424.7 out of 5 Stars. 42 reviewsSave withPickup todayDelivery todayShipping, arrives in 3+ daysMayco Stroke & Coat Wonderglaze Glaze, SC-1 Pink-A-Boo, Opaque, Pint $16.61 Was $25.99
 Now$1661current price Now $16.61, Was $25.99$25.99+$9.95 shipping
Now$1661current price Now $16.61, Was $25.99$25.99+$9.95 shippingMayco Stroke & Coat Wonderglaze Glaze, SC-1 Pink-A-Boo, Opaque, Pint
Shipping, arrives in 3+ daysColorobbia Liquid Bright Glass Gold Overglaze for Kiln Fired Glass (Pkg/1) $54.80
 2 optionsAvailable in additional 2 options$5480current price $54.80Options from $54.80 – $97.50
2 optionsAvailable in additional 2 options$5480current price $54.80Options from $54.80 – $97.50Colorobbia Liquid Bright Glass Gold Overglaze for Kiln Fired Glass (Pkg/1)
Shipping, arrives in 3+ daysMayco Stroke & Coat Wonderglaze Glaze, SC-31 The Blues, Opaque, Pint $34.37
 $3437current price $34.37
$3437current price $34.37Mayco Stroke & Coat Wonderglaze Glaze, SC-31 The Blues, Opaque, Pint
Shipping, arrives in 3+ daysSpectrum Stoneware Glaze - Gold Rain, Pint $16.00
 $1600current price $16.00+$9.95 shipping
$1600current price $16.00+$9.95 shippingSpectrum Stoneware Glaze - Gold Rain, Pint
Shipping, arrives in 3+ daysMayco Stroke & Coat Wonderglaze Glaze, SC-89 Cutie Pie Coral, Opaque, Pint $16.61 Was $20.50
 Now$1661current price Now $16.61, Was $20.50$20.50+$9.95 shipping
Now$1661current price Now $16.61, Was $20.50$20.50+$9.95 shippingMayco Stroke & Coat Wonderglaze Glaze, SC-89 Cutie Pie Coral, Opaque, Pint
11 out of 5 Stars. 1 reviewsShipping, arrives in 3+ daysSax Gloss Glazes, 1 Pint Containers, Assorted Colors, Set of 12 $142.06
 $14206current price $142.06
$14206current price $142.06Sax Gloss Glazes, 1 Pint Containers, Assorted Colors, Set of 12
45 out of 5 Stars. 4 reviewsShipping, arrives in 3+ daysSpeedball Art 16 oz. (pint) Earthenware Glaze--Tan $24.89 $24.89/count
 $2489current price $24.89$24.89/count
$2489current price $24.89$24.89/countSpeedball Art 16 oz. (pint) Earthenware Glaze--Tan
Shipping, arrives in 3+ daysMayco Stroke & Coat Wonderglaze Glaze, SC-11 Blue Yonder, Opaque, Pint $16.61 Was $30.14
 Now$1661current price Now $16.61, Was $30.14$30.14+$9.95 shipping
Now$1661current price Now $16.61, Was $30.14$30.14+$9.95 shippingMayco Stroke & Coat Wonderglaze Glaze, SC-11 Blue Yonder, Opaque, Pint
Shipping, arrives in 3+ daysSpeedball Art 16 oz. (pint) Earthenware Glaze--Honey $24.89 $24.89/count
 $2489current price $24.89$24.89/count
$2489current price $24.89$24.89/countSpeedball Art 16 oz. (pint) Earthenware Glaze--Honey
Shipping, arrives in 3+ daysIndia Clay Mini Clay Pot Broken 200 Grams $13.99
 $1399current price $13.99
$1399current price $13.99India Clay Mini Clay Pot Broken 200 Grams
94.3 out of 5 Stars. 9 reviewsSave withShipping, arrives in 3+ days
Customer ratings & reviews
0 ratings|0 reviews
This item does not have any reviews yet
